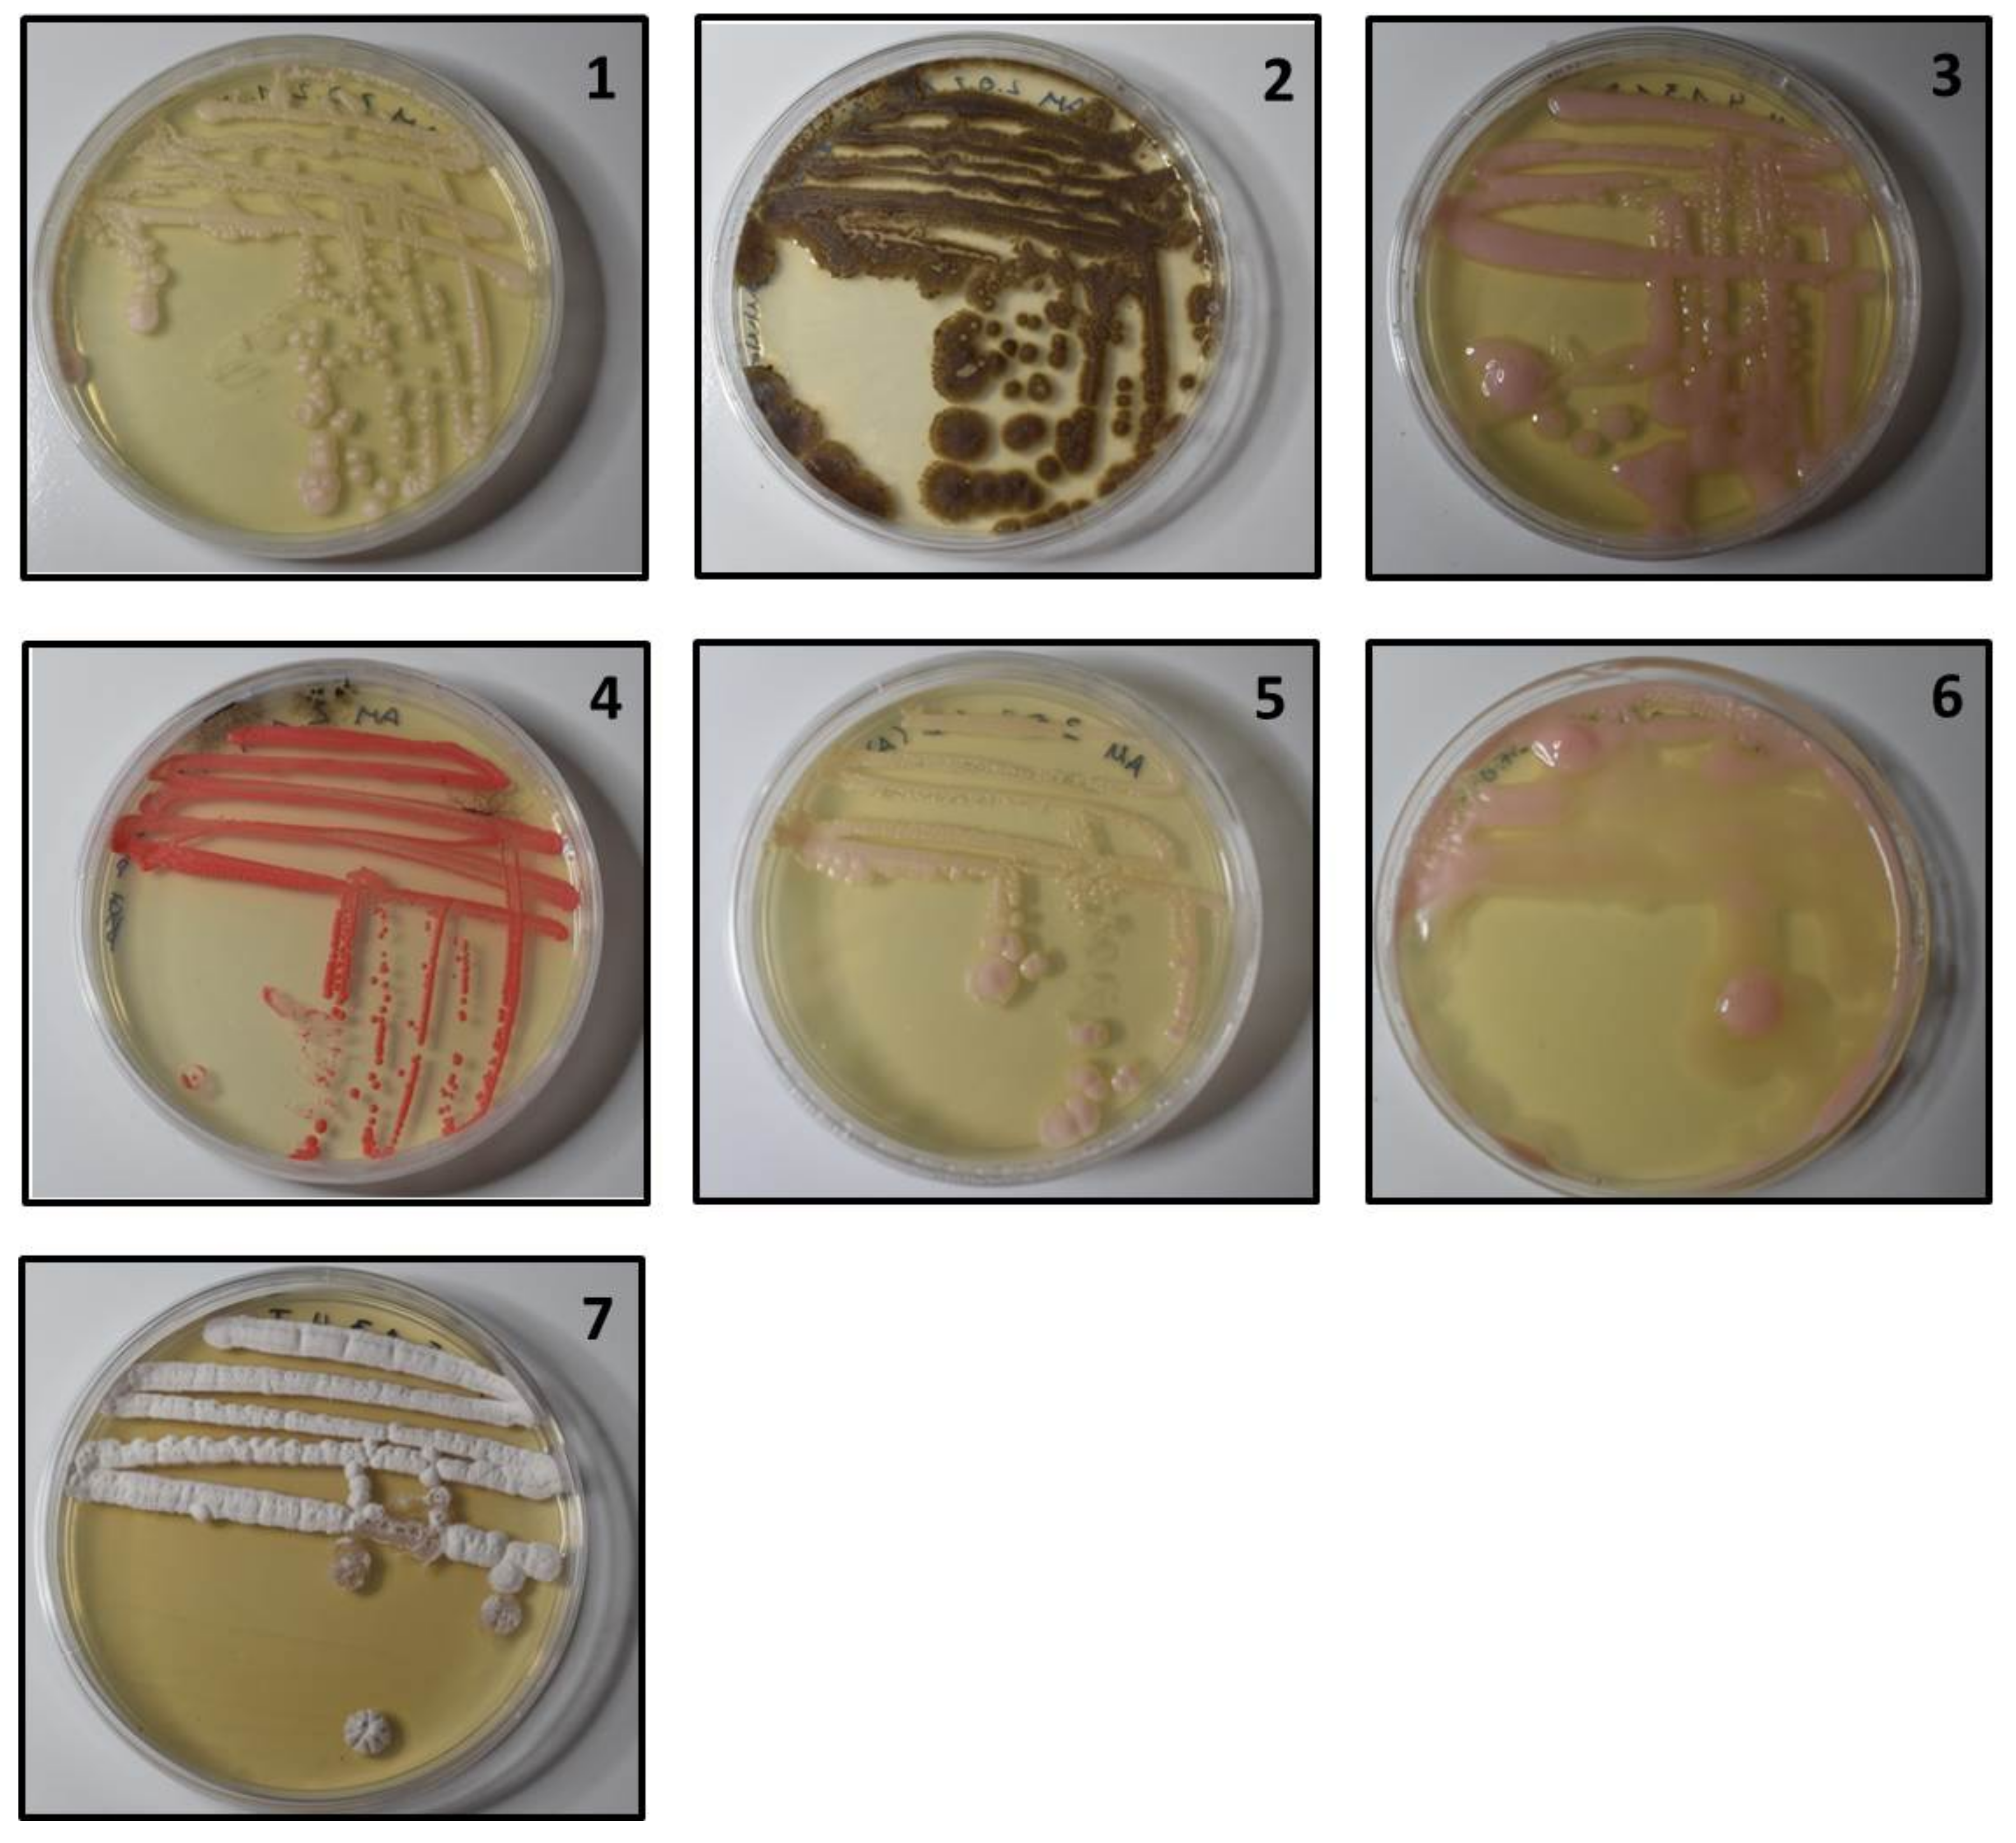

Unusual Non-Saccharomyces Yeasts Isolated from Unripened Grapes without Antifungal Treatments
Abstract
1. Introduction
2. Materials and Methods
2.1. Samples
2.2. Yeasts Isolation
2.3. Physiological Characterization of Isolates
2.4. Molecular Identification Using rDNA Sequence
2.5. Enzymatic Characterization
2.5.1. Protease Activity
2.5.2. Beta-Glucosidase Activity
2.5.3. Pectinase Activity
2.5.4. Xylanase Activity
2.5.5. Lipase Activity
3. Result
3.1. Morphological Groups
3.2. Population Dynamics
3.3. Physiological Characterization
3.4. Molecular Identification
3.5. Enzymatic Activities
4. Discussion
Author Contributions
Funding
Conflicts of Interest
Abbreviations
| PCR | Polymerase Chain Reaction |
| RFLP | Restriction Fragment Length Polymorphism |
References
- Arévalo Villena, M.; Úbeda Iranzo, J.; Cordero Otero, R.; Briones Pérez, A. Optimization of a rapid method for studying the cellular location of β-glucosidase activity in wine yeasts. J. Appl. Microbiol. 2005, 99, 558–564. [Google Scholar] [CrossRef] [PubMed]
- Jolly, N.; Varela, C.; Pretorius, I. Not your ordinary yeast: Non-Saccharomyces yeasts in wine production uncovered. FEMS Yeast Res. 2014, 14, 215–237. [Google Scholar] [CrossRef] [PubMed]
- Torija, M.; Rozès, N.; Poblet, M.; Guillamón, J.; Mas, A. Yeast population dynamics in spontaneous fermentations: Comparison between two different wine-producing areas over a period of three years. Antonie Van Leeuwenhoek Int. J. Gen. Mol. Microbiol. 2001, 79, 345–352. [Google Scholar] [CrossRef]
- Combina, M.; Mercado, L.; Borgo, P.; Elia, A.; Jofré, V.; Ganga, A.; Martinez, C.; Catania, C. Yeasts associated to Malbec grape berries from Mendoza, Argentina. J. Appl. Microbiol. 2005, 98, 1055–1061. [Google Scholar] [CrossRef]
- Goddard, M.; Anfang, N.; Tang, R.; Gardner, R.; Jun, C. A distinct population of Saccharomyces cerevisiae in New Zealand: Evidence for local dispersal by insects and human-aided global dispersal in oak barrels. Environ. Microbiol. 2010, 12, 63–73. [Google Scholar] [CrossRef]
- Gayevskiy, V.; Goddard, M. Geographic delineations of yeast communities and populations associated with vines and wines in New Zealand. ISME J. 2012, 6, 1281–1290. [Google Scholar] [CrossRef] [PubMed]
- Romano, P.; Fiore, C.; Paraggio, M.; Caruso, M.; Capece, A. Function of yeast species and strains in wine flavour. Int. J. Food Microbiol. 2003, 86, 169–180. [Google Scholar] [CrossRef]
- Renault, P.; Miot-Sertier, C.; Marullo, P.; Hernández-Orte, P.; Lagarrigue, L.; Lonvaud-Funel, A.; Bely, M. Genetic characterization and phenotypic variability in Torulaspora delbrueckii species: Potential applications in the wine industry. Int. J. Food Microbiol. 2009, 134, 201–210. [Google Scholar] [CrossRef]
- Zohre, D.; Erten, H. The influence of Kloeckera apiculata and Candida pulcherrima yeasts on wine fermentation. Process Biochem. 2002, 38, 319–324. [Google Scholar] [CrossRef]
- Fleet, G.H. Yeast interactions and wine flavour. Int. J. Food Microbiol. 2003, 86, 11–22. [Google Scholar] [CrossRef]
- Jolly, N.; Augustyn, O.; Pretorius, I. The use of Candida pulcherrima in combination with Saccharomyces cerevisiae for the production of Chenin blanc wine. S. Afr. J. Enololy Vitic. 2003, 24, 63–69. [Google Scholar] [CrossRef]
- Ludovico, P.; Sousa, M.; Silva, M.; Leão, C.; Côrte-Real, M. Saccharomyces cerevisiae commits to a programmed cell death process in response to acetic acid. Microbiology 2001, 147, 2409–2415. [Google Scholar] [CrossRef] [PubMed]
- Ciani, M.; Comitini, F.; Mannazzu, I.; Domizio, P. Controlled mixed culture fermentation: A new perspective on the use of non-Saccharomyces yeasts in winemaking. FEMS Yeast Res. 2010, 10, 123–133. [Google Scholar] [CrossRef] [PubMed]
- Styger, G.; Jacobson, D.; Bauer, F. Identifying genes that impact on aroma profiles produced by Saccharomyces cerevisiae and the production of higher alcohols. Appl. Microbiol. Biotechnol. 2011, 91, 713–730. [Google Scholar] [CrossRef] [PubMed]
- Mateo, J.; Peris, L.; Ibañez, C.; Maicas, S. Characterization of glycolytic activities from non-Saccharomyces yeasts isolated from Bobal musts. J. Ind. Microbiol. Biotechnol. 2011, 38, 347–354. [Google Scholar] [CrossRef] [PubMed]
- Howell, K.; Cozzolino, D.; Bartowsky, E.; Fleet, G.; Henschke, P. Metabolic profiling as a tool for revealing Saccharomyces interactions during wine fermentation. FEMS Yeast Res. 2006, 6, 91–101. [Google Scholar] [CrossRef] [PubMed]
- Anfang, N.; Brajkovich, M.; Goddard, M. Co-fermentation with Pichia kluyveri increases varietal thiol concentrations in sauvignon blanc. Aust. J. Grape Wine Res. 2009, 15, 1–8. [Google Scholar] [CrossRef]
- Hildebrandt, A.; Guillamón, M.; Lacorte, S.; Tauler, R.; Barceló, D. Impact of pesticides used in agriculture and vineyards to surface and groundwater quality (North Spain). Water Res. 2008, 42, 3315–3326. [Google Scholar] [CrossRef]
- Miguéns, T.; Leirós, M.C.; Gil-Sotres, F.; Trasar-Cepeda, C. Biochemical properties of vineyard soils in Galicia, Spain. Sci. Total Environ. 2007, 378, 218–222. [Google Scholar] [CrossRef]
- Milanović, V.; Comitini, F.; Ciani, M. Grape berry yeast communities: Influence of fungicide treatments. Int. J. Food Microbiol. 2013, 161, 240–246. [Google Scholar] [CrossRef]
- Wirth, F.; Goldani, L. Epidemiology of Rhodotorula: An emerging pathogen. Interdiscip. Perspect. Infect. Dis. 2012, 2012. [Google Scholar] [CrossRef] [PubMed]
- O’Donnell, K.; Cigelnik, E.; Nirenberg, H. Molecular systematics and phylogeography of the Gibberella fujikuroi species complex. Mycologia 1998, 90, 465–493. [Google Scholar] [CrossRef]
- Esteve-Zarzoso, B.; Manzanares, P.; Ramon, D.; Querol, A. The role of non-Saccharomyces yeasts in industrial winemaking. Int. Microbiol. 1998, 1, 143–148. [Google Scholar]
- Charoenchai, C.; Fleet, G.H.; Henschke, P.A.; Todd, B.E.N.T. Screening of non-Saccharomyces wine yeasts for the presence of extracellular hydrolytic enzymes. Aust. J. Grape Wine Res. 1997, 3, 2–8. [Google Scholar] [CrossRef]
- Maksimova, I.; Chernov, I. Community structure of yeast fungi in forest biogeocenoses. Microbiology 2004, 73, 474–481. [Google Scholar] [CrossRef]
- Martins, G.; Vallance, J.; Mercier, A.; Albertin, W.; Stamatopoulos, P.; Rey, P.; Lonvaud, A.; Masneuf-Pomarède, I. Influence of the farming system on the epiphytic yeasts and yeast-like fungi colonizing grape berries during the ripening process. Int. J. Food Microbiol. 2014, 177, 21–28. [Google Scholar] [CrossRef] [PubMed]
- Sáenz-Navajas, M.P.; Avizcuri, J.M.; Ballester, J.; Fernández-Zurbano, P.; Ferreira, V.; Peyron, D.; Valentin, D. Sensory-active compounds influencing wine experts’ and consumers’ perception of red wine intrinsic quality. LWT Food Sci. Technol. 2015, 60, 400–411. [Google Scholar] [CrossRef]
- Boulton, R.; Singleton, V.; Bisson, L.; Kunkee, R. Yeast and Biochemistry of Ethanol Fermentation. In Principles and Practices of Winemaking; Chapman & Hall: London, UK, 1996; Chapter 3; pp. 139–172. [Google Scholar]
- Barata, A.; Malfeito-Ferreira, M.; Loureiro, V. The microbial ecology of wine grape berries. Int. J. Food Microbiol. 2012, 153, 243–259. [Google Scholar] [CrossRef] [PubMed]
- Hernández, J.; Trujillo, Y.; Durán, D. Contenido fenólico e identificación de levaduras de importancia vínica de la uva isabella (Vitis labrusca) procedente de Villa del Rosario (Norte de Santander). Vitae 2011, 18, 17–25. [Google Scholar]
- Scorzetti, G.; Petrescu, I.; Yarrow, D.; Fell, J. Cryptococcus adeliensis sp. nov., a xylanase producing basidiomycetous yeast from Antarctica. Antonie Van Leeuwenhoek Int. J. Gen. Mol. Microbiol. 2000, 77, 153–157. [Google Scholar] [CrossRef]
- Cheng, K.C.; Demirci, A.; Catchmark, J.; Puri, V. Modeling of pullulan fermentation by using a color variant strain of Aureobasidium pullulans. J. Food Eng. 2010, 98, 353–359. [Google Scholar] [CrossRef]
- Agarbati, A.; Canonico, L.; Ciani, M.; Comitini, F. The impact of fungicide treatments on yeast biota of Verdicchio and Montepulciano grape varieties. PLoS ONE 2019, 14. [Google Scholar] [CrossRef] [PubMed]
- Escribano-Viana, R.; López-Alfaro, I.; López, R.; Santamaría, P.; Gutiérrez, A.; González-Arenzana, L. Impact of chemical and biological fungicides applied to grapevine on grape biofilm, must, and wine microbial diversity. Front. Microbiol. 2018, 9. [Google Scholar] [CrossRef] [PubMed]
- Ocón, E.; Garijo, P.; Santamaría, P.; López, R.; Olarte, C.; Gutiérrez, A.; Sanz, S. Comparison of culture media for the recovery of airborne yeast in wineries. Lett. Appl. Microbiol. 2013, 57, 241–248. [Google Scholar] [CrossRef] [PubMed]
- Renouf, V.; Claisse, O.; Lonvaud-Funel, A. Understanding the microbial ecosystem on the grape berry surface through numeration and identification of yeast and bacteria. Aust. J. Grape Wine Res. 2005, 11, 316–327. [Google Scholar] [CrossRef]
- Maicas, S.; Mateo, J. Hydrolysis of terpenyl glycosides in grape juice and other fruit juices: A review. Appl. Microbiol. Biotechnol. 2005, 67, 322–335. [Google Scholar] [CrossRef]
- López, S.; Mateo, J.; Maicas, S. Characterisation of hanseniaspora isolates with potential aromaenhancing properties in muscat wines. S. Afr. J. Enol. Vitic. 2014, 35, 292–303. [Google Scholar]
- Madrigal, T.; Maicas, S.; Mateo Tolosa, J. Glucose and ethanol tolerant enzymes produced by Pichia (Wickerhamomyces) isolates from enological ecosystems. Am. J. Enol. Vitic. 2013, 64, 126–133. [Google Scholar] [CrossRef]
- Gaensly, F.; Agustini, B.; da Silva, G.; Picheth, G.; Bonfim, T. Autochthonous yeasts with β-glucosidase activity increase resveratrol concentration during the alcoholic fermentation of Vitis labrusca grape must. J. Funct. Foods 2015, 19, 288–295. [Google Scholar] [CrossRef]
- Cramer, A.; Vlassides, S.; Block, D. Kinetic model for nitrogen-limited wine fermentations. Biotechnol. Bioeng. 2002, 77, 49–60. [Google Scholar] [CrossRef]
- Swiegers, J.; Bartowsky, E.; Henschke, P.; Pretorius, I. Yeast and bacterial modulation of wine aroma and flavour. Aust. J. Grape Wine Res. 2005, 11, 139–173. [Google Scholar] [CrossRef]
- Strauss, M.; Jolly, N.; Lambrechts, M.; Van Rensburg, P. Screening for the production of extracellular hydrolytic enzymes by non-Saccharomyces wine yeasts. J. Appl. Microbiol. 2001, 91, 182–190. [Google Scholar] [CrossRef] [PubMed]
- Mateo, J.; Maicas, S.; Thieen, C. Biotechnological characterisation of exocellular proteases produced by enological Hanseniaspora isolates. Int. J. Food Sci. Technol. 2015, 50, 218–225. [Google Scholar] [CrossRef]
| Group | Time (Days) | ||||
|---|---|---|---|---|---|
| 0 | 14 | 23 | 31 | 38 | |
| 1 | 3.33 × 10 (10.6) * | 3.67 × 10 (15.4) | 3.33 × 10 (14.3) | 1.66 × 10 (10.5) | 3.80 × 10 (11.6) |
| 2 | nd | 4.66 × 10 (12.8) | 2.30 × 10 (16.8) | 9.66 × 10 (13.6) | 6.66 × 10 (16.2) |
| 3 | nd | 1.00 × 10 (9.6) | nd | nd | 3.00 × 10 (14.9) |
| 4 | nd | 6.67 × 10 (11.2) | nd | nd | nd |
| 5 | nd | nd | 2.33 × 10 (13.2) | nd | nd |
| 6 | nd | nd | 2.33 × 10 (10.7) | 3.33 × 10 (10.5) | nd |
| 7 | nd | nd | nd | nd | 1.54 × 10 (9.8) |
| Total | 3.33 × 10 | 5.19 × 10 | 3.10 × 10 | 1.17 × 10 | 1.67 × 10 |
| Group | Carbohydrate Assayed | |||||||||||||||||||
|---|---|---|---|---|---|---|---|---|---|---|---|---|---|---|---|---|---|---|---|---|
| 0 | 1 | 2 | 3 | 4 | 5 | 6 | 7 | 8 | 9 | 10 | 11 | 12 | 13 | 14 | 15 | 16 | 17 | 18 | 19 | |
| 1 | - | + | - | - | - | + | + | + | - | + | + | - | + | - | - | - | + | - | - | - |
| 2 | - | + | - | - | + | + | + | + | + | + | + | + | + | + | + | - | + | + | - | + |
| 3 | - | + | - | - | + | + | + | + | + | + | + | + | + | + | + | - | + | + | - | + |
| 4 | - | + | - | - | + | - | + | + | + | + | + | + | + | + | + | - | + | + | - | + |
| 5 | - | + | + | - | - | + | + | + | + | + | + | - | + | - | + | - | + | + | - | + |
| 6 | - | + | + | - | - | + | + | + | + | + | + | + | + | - | - | - | + | + | - | + |
| 7 | - | + | + | + | - | + | + | + | + | + | + | + | + | + | + | - | + | + | + | + |
| Group | Carbohydrate Assayed | ||||||||||||||||
|---|---|---|---|---|---|---|---|---|---|---|---|---|---|---|---|---|---|
| 0 | 1 | 2 | 3 | 4 | 5 | 6 | 7 | 8 | 9 | A | B | C | D | E | F | ||
| 1 | 1 | - | - | + | + | - | + | + | + | + | + | - | - | + | - | - | - |
| 0 | + | + | - | - | + | + | - | - | + | + | - | - | + | - | - | + | |
| 2 | 1 | + | - | + | + | + | + | + | + | + | + | - | - | + | - | + | - |
| 0 | + | + | - | - | + | + | + | + | - | + | - | - | + | + | - | + | |
| 3 | 1 | - | - | + | - | - | + | + | + | + | + | + | + | + | - | - | - |
| 0 | + | + | - | - | - | + | - | - | + | + | + | - | + | - | - | + | |
| 4 | 1 | - | - | + | + | - | + | + | + | - | + | - | - | + | - | + | - |
| 0 | + | - | + | + | - | + | + | + | - | + | - | - | + | - | - | - | |
| 5 | 1 | - | - | + | - | - | + | + | + | - | + | + | - | + | - | - | - |
| 0 | - | + | - | - | - | + | - | - | + | - | - | - | + | - | - | + | |
| 6 | 1 | - | - | + | + | - | + | + | + | + | + | + | + | + | + | + | - |
| 0 | + | + | + | + | + | + | - | - | + | + | - | - | + | - | - | + | |
| 7 | 1 | - | - | + | + | + | - | - | + | + | + | - | - | + | + | + | - |
| 0 | + | - | + | + | + | + | + | + | - | + | + | - | + | - | - | - | |
| Group | 5.8S-ITS-RFLP Analysis (bp) | Closest Relative Species | Matching Nucleotides (%) | ||||
|---|---|---|---|---|---|---|---|
| PCR | HhaI | HaeIII | HindIII | HinfI | |||
| 1 | 630 | 340 + 280 + 190 | 500 | 600 | 260 + 250 + 150 | Metschnikowia pulcherrima | 99.5 |
| 2 | 500 | 160+ 100 | 150 + 110 | 500 | 280 + 180 + 140 | Aureobasidium pullulans | 99.8 |
| 3 | 600 | 300 + 260 | 470 | 650 | 320 + 250 | Crytococcus uzbekistanensis | 99.5 |
| 4 | 740 | 320 + 270 +210 | 390 + 270 + 210 | 580 | 220 + 170 | Rhodotorula mucilaginosa | 99.9 |
| 5 | 700 | 300 + 270 | 700 | 700 | 310 + 240 | Crytococcus adeliensis | 99.5 |
| 6 | 600 | 340 + 280 | 280 + 200 | 300 + 260 | 240 | Crytococcus sp. CF-285748 | 99.7 |
| 7 | 630 | 630 | 270 | 630 | 270 + 150 | Quambalaria cyanescens | 99.5 |
| Microorganism | Enzymatic Activities | ||||
|---|---|---|---|---|---|
| -glucosidase | Protease | Lipase | Xylanase | Pectinase | |
| Crytococcus adeliensis | + | + | - | - | - |
| Cryptococcus sp. CF-285748 | + | + | - | - | - |
| Metschnikowia pulcherrima | + | + | - | - | - |
| Aureobasidium pullulans | + | + | - | - | - |
| Cryptococcus uzbekistanensis | - | + | - | - | - |
| Rhodotorula mucilaginosa | + | + | - | - | - |
| Quambalaria cyanescens | + | + | + | - | - |
© 2020 by the authors. Licensee MDPI, Basel, Switzerland. This article is an open access article distributed under the terms and conditions of the Creative Commons Attribution (CC BY) license (http://creativecommons.org/licenses/by/4.0/).
Share and Cite
Mateo, J.J.; Garcerà, P.; Maicas, S. Unusual Non-Saccharomyces Yeasts Isolated from Unripened Grapes without Antifungal Treatments. Fermentation 2020, 6, 41. https://doi.org/10.3390/fermentation6020041
Mateo JJ, Garcerà P, Maicas S. Unusual Non-Saccharomyces Yeasts Isolated from Unripened Grapes without Antifungal Treatments. Fermentation. 2020; 6(2):41. https://doi.org/10.3390/fermentation6020041
Chicago/Turabian StyleMateo, José Juan, Patricia Garcerà, and Sergi Maicas. 2020. "Unusual Non-Saccharomyces Yeasts Isolated from Unripened Grapes without Antifungal Treatments" Fermentation 6, no. 2: 41. https://doi.org/10.3390/fermentation6020041
APA StyleMateo, J. J., Garcerà, P., & Maicas, S. (2020). Unusual Non-Saccharomyces Yeasts Isolated from Unripened Grapes without Antifungal Treatments. Fermentation, 6(2), 41. https://doi.org/10.3390/fermentation6020041

